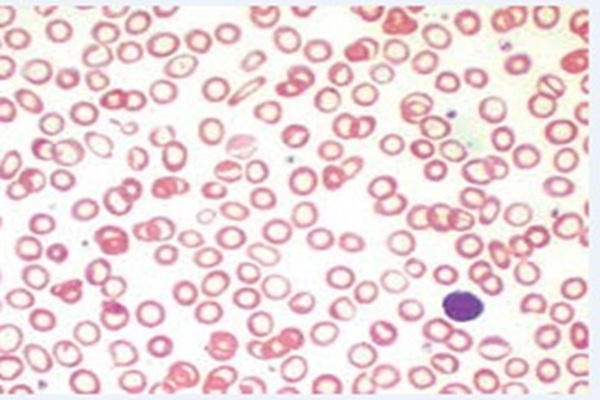

Teaching/Techniques Adopted
Project activity: e-collage, e-posters, concept mapping and in the form of skits

Image and Case - based studies with charts

JSS MC Path app for practical classes

JSS MC Path app for practical classes

Whole Slide Imaging
Whole Slide Imaging

Skillful Procedures- Bone marrow aspiration/ biopsy; Fine needle aspiration cytology; Core Biopsy/ Staining Techniques
Biopsy Review








Interdepartmental case discussion/ Integrated teaching with other departments


Gross specimen/ Microscopy discussion




MCQs, Picture Quiz, Crossword

Evaluation
| Formative Theory Assessment – Essays, Short Answers, MCQ’s |
| OSPE |
| SGD, Case based scenarios, project activity |
| Certifiable skills |
| Subject seminars |
| Morbid Anatomy discussion |
| Biopsy Rapid reviews |
| Journal Reviews |